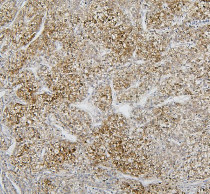

ARG42966
anti-CYP2C19 antibody
anti-CYP2C19 antibody for IHC-Formalin-fixed paraffin-embedded sections,Western blot and Human,Mouse,Rat
Overview
| Product Description | Rabbit Polyclonal antibody recognizes CYP2C19 |
|---|---|
| Tested Reactivity | Hu, Ms, Rat |
| Tested Application | IHC-P, WB |
| Host | Rabbit |
| Clonality | Polyclonal |
| Isotype | IgG |
| Target Name | CYP2C19 |
| Antigen Species | Human |
| Immunogen | Synthetic peptide corresponding to a sequence of Human CYP2C19. (QNQQSEFTIENLVITAADLLGAGTETT) |
| Conjugation | Un-conjugated |
| Alternate Names | Mephenytoin 4-hydroxylase; P450IIC19; P450C2C; Cytochrome P450 2C19; Cytochrome P450-254C; EC 1.14.13.49; EC 1.14.13.48; CYP2C; S; R; CYPIIC17; CPCJ; EC 1.14.13.80; EC 1.14.13.-; CYPIIC19; Cytochrome P450-11A |
Application Instructions
| Application Suggestion |
|
||||||
|---|---|---|---|---|---|---|---|
| Application Note | IHC-P: Antigen Retrieval: Heat mediation was performed in Citrate buffer (pH 6.0) for 20 min. * The dilutions indicate recommended starting dilutions and the optimal dilutions or concentrations should be determined by the scientist. |
||||||
| Observed Size | ~ 56 kDa |
Properties
| Form | Liquid |
|---|---|
| Purification | Affinity purification with immunogen. |
| Buffer | 0.2% Na2HPO4, 0.9% NaCl, 0.05% Sodium azide and 4% Trehalose. |
| Preservative | 0.05% Sodium azide |
| Stabilizer | 4% Trehalose |
| Concentration | 0.5 mg/ml |
| Storage Instruction | For continuous use, store undiluted antibody at 2-8°C for up to a week. For long-term storage, aliquot and store at -20°C or below. Storage in frost free freezers is not recommended. Avoid repeated freeze/thaw cycles. Suggest spin the vial prior to opening. The antibody solution should be gently mixed before use. |
| Note | For laboratory research only, not for drug, diagnostic or other use. |
Bioinformation
| Database Links | |
|---|---|
| Gene Symbol | CYP2C19 |
| Gene Full Name | cytochrome P450, family 2, subfamily C, polypeptide 19 |
| Background | This gene encodes a member of the cytochrome P450 superfamily of enzymes. The cytochrome P450 proteins are monooxygenases which catalyze many reactions involved in drug metabolism and synthesis of cholesterol, steroids and other lipids. This protein localizes to the endoplasmic reticulum and is known to metabolize many xenobiotics, including the anticonvulsive drug mephenytoin, omeprazole, diazepam and some barbiturates. Polymorphism within this gene is associated with variable ability to metabolize mephenytoin, known as the poor metabolizer and extensive metabolizer phenotypes. The gene is located within a cluster of cytochrome P450 genes on chromosome 10q24. [provided by RefSeq, Jul 2008] |
| Function | A cytochrome P450 monooxygenase involved in the metabolism of polyunsaturated fatty acids (PUFA) (PubMed:18577768, PubMed:19965576, PubMed:20972997). Mechanistically, uses molecular oxygen inserting one oxygen atom into a substrate, and reducing the second into a water molecule, with two electrons provided by NADPH via cytochrome P450 reductase (NADPH--hemoprotein reductase) (PubMed:18577768, PubMed:19965576, PubMed:20972997). Catalyzes the hydroxylation of carbon-hydrogen bonds. Hydroxylates PUFA specifically at the omega-1 position (PubMed:18577768). Catalyzes the epoxidation of double bonds of PUFA (PubMed:20972997, PubMed:19965576). Also metabolizes plant monoterpenes such as limonene. Oxygenates (R)- and (S)-limonene to produce carveol and perillyl alcohol (PubMed:11950794). Responsible for the metabolism of a number of therapeutic agents such as the anticonvulsant drug S-mephenytoin, omeprazole, proguanil, certain barbiturates, diazepam, propranolol, citalopram and imipramine. Hydroxylates fenbendazole at the 4' position (PubMed:23959307). [UniProt] |
| Cellular Localization | Endoplasmic reticulum membrane; Peripheral membrane protein. Microsome membrane; Peripheral membrane protein. [UniProt] |
| Calculated MW | 56 kDa |
Images (4) Click the Picture to Zoom In
-
ARG42966 anti-CYP2C19 antibody IHC-P image
Immunohistochemistry: Paraffin-embedded Rat liver tissue. Antigen Retrieval: Heat mediation was performed in Citrate buffer (pH 6.0) for 20 min. The tissue section was blocked with 10% goat serum. The tissue section was then stained with ARG42966 anti-CYP2C19 antibody at 1 µg/ml dilution, overnight at 4°C.
-
ARG42966 anti-CYP2C19 antibody WB image
Western blot: 50 µg of sample under reducing conditions. Rat liver lysate stained with ARG42966 anti-CYP2C19 antibody at 0.5 µg/ml dilution, overnight at 4°C.
-
ARG42966 anti-CYP2C19 antibody IHC-P image
Immunohistochemistry: Paraffin-embedded Human liver cancer tissue. Antigen Retrieval: Heat mediation was performed in Citrate buffer (pH 6.0) for 20 min. The tissue section was blocked with 10% goat serum. The tissue section was then stained with ARG42966 anti-CYP2C19 antibody at 1 µg/ml dilution, overnight at 4°C.
-
ARG42966 anti-CYP2C19 antibody IHC-P image
Immunohistochemistry: Paraffin-embedded Mouse liver tissue. Antigen Retrieval: Heat mediation was performed in Citrate buffer (pH 6.0) for 20 min. The tissue section was blocked with 10% goat serum. The tissue section was then stained with ARG42966 anti-CYP2C19 antibody at 1 µg/ml dilution, overnight at 4°C.